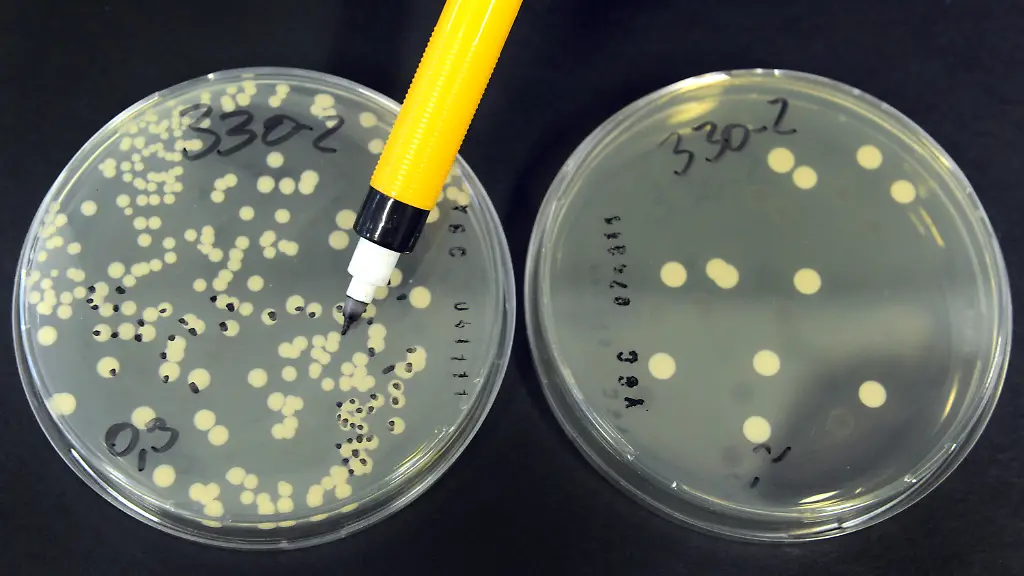

Forscher suchen nach B12-QuelleHefe soll Raumfahrern Vitamine liefern
Je weiter Exkursionen ins Weltall führen, desto schwieriger wird die Versorgung der Raumfahrer. Der Mangel an Vitamin B12 beschäftigt nun Wissenschaftler. Mit einem neuen Experiment soll geklärt werden, ob Hefe im All als Vitamin-B12-Quelle funktionieren kann.
Entwässerte Wurst-Pastetchen sowie Lachssalat und Schokopudding: Auf ihrer historischen Reise zum Mond tragen die drei US-Astronauten im Juli 1969 auch einen Gruß von der irdischen Ernährungswissenschaft im Gepäck. Rund 50 Jahre später strebt die Raumfahrt längst fernere Ziele als den Erdtrabanten an - etwa den Mars. Je weiter allerdings die kosmischen Exkursionen führen, desto wichtiger wird die Nahrung. "Alle wollen zum Mond und zum Mars, aber die Ressourcenfrage ist ungeklärt - besonders für einen Aufenthalt im All, der länger als drei Monate dauert", sagt Experte Jens Hauslage.
Der Wissenschaftler vom Deutschen Zentrum für Luft- und Raumfahrt (DLR) wird Mitte Juni in Schweden den Start einer Rakete betreuen, die auch 20 Gramm Hefe an Bord hat: eine kleine Menge für die Forschung, aber vielleicht ein großer Schritt für die Raumfahrt. Denn Hauslage und seine Partner in der Pfalz interessiert, ob Hefe in der Schwerelosigkeit B12 bilden kann - das Vitamin ist für Menschen wichtig. Normalerweise wird es zusammen mit Fleisch aufgenommen, aber das Weltall fordert Alternativen. "Wenn wir die B12-Frage geklärt haben", meint Hauslage, "haben wir ein Problem weniger."
Seine Projektpartner in Rheinland-Pfalz sind der Weincampus Neustadt und das BierProjekt Landau eG. "Wir Südpfälzer wollten wissen, ob Hefe unter solchen Bedingungen überlebt", sagt Dominik Rödel aus Landau. Deswegen habe man beim Raumfahrtzentrum angefragt. "Das DLR experimentiert mit Hefe zur Vitamin-B12-Versorgung von Menschen in geschlossenen Systemen und hat uns mit ins Boot genommen." Durch das Einbetten in bestehende Versuche entstehe nur organisatorischer Aufwand, Kosten würden fast keine anfallen, sagt Rödel. Die Hefe fliege als kleinstes von insgesamt zehn Experimenten in der Rakete mit, erzählt Hauslage.
Hefe unter Stress
Und so soll es ablaufen: Voraussichtlich am 11. Juni hebt eine zwölf Meter hohe Rakete vom Startplatz bei Kiruna ab. Der fast drei Tonnen schwere Flugkörper steigt bis auf 248 Kilometer Höhe und kehrt nach sechs Minuten in der Schwerelosigkeit zur Erde zurück - am Fallschirm. "Wir wollen uns molekularbiologisch anschauen, was Hefezellen in dieser Stress-Situation herstellen", sagt Hauslage. "Nach der Bergung geht die Hefe gekühlt per Express zum Weincampus Neustadt. Die Untersuchung dort dauert sicher mehrere Wochen."
Ernährung war in der Raumfahrt schon immer ein zentrales Thema. Der US-Astronaut John Young nahm 1965 ein Corned Beef Sandwich mit an Bord und verärgerte durch die umherschwebenden Brotkrümel die Techniker im Kontrollzentrum. Seitdem hat sich viel getan - kalte Paste in Aluminiumtuben und Happen in Würfelform sind Vergangenheit. Die Speisekarte der Internationalen Raumstation ISS in rund 400 Kilometer Höhe bietet heute Dutzende Möglichkeiten.
Experimentiert wurde auch schon mit Hefe, zum Beispiel 1997 in Zusammenarbeit mit dem Strahlenzentrum Gießen (Hessen) an Bord der damaligen Raumstation "Mir". Der Unterschied zu bisherigen Hefe-Experimenten sei, dass die Forscher diesmal über sogenannte Kontrollgruppen auf der Erde verfügten, sagt Rödel. Schon seit einiger Zeit werden auf der ISS als Experiment zum Beispiel Salat und Tomaten angebaut, um zumindest teilweise die Versorgung der Raumfahrer mit frischer Kost sicherzustellen.